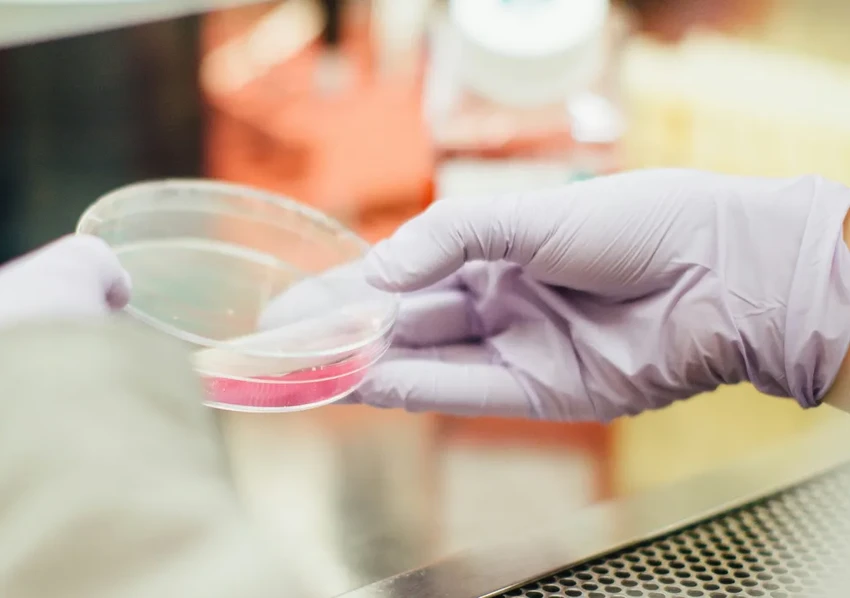
Искусственный интеллект: где поставить запятую в «использовать нельзя бояться»?

Искусственный интеллект: где поставить запятую в «использовать нельзя бояться»?
Компьютер в чашке Петри
Как платформа из нейронов коры головного мозга крыс научилась играть в DOOM
Развитие ИИ напоминает гонку без финишной черты. Ещё вчера мы удивлялись распознаванию котиков на фото, а сегодня уже нервно поглядываем на чашку Петри. Да-да, ту самую. Летом 2023 года учёный под псевдонимом The Thought Emporium создал из нейронов мозга крысы… игровую платформу, способную проходить DOOM. Это не привычный нам код — нейроны учились по звуковым сигналам, формируя паттерны для движения и стрельбы. Жутковато? Ещё бы.
Вся эта «мыслительная» система умещается в лабораторной посуде. А теперь задумайтесь: наши суперкомпьютеры размером с ангар едва дотягивают по числу нейронов до мозга грызуна и прожорливы как драконы. Оставим в стороне этику (хотя как тут её оставить?). Если подобные «био-компьютеры» окажутся жизнеспособными, они могут затмить гигантские дата-центры. Правда, готово ли наше общество принять подобное? В некоторых странах к таким экспериментам отнесутся спокойнее, в других — категорически нет. Мы стоим на пороге выбора, даже не осознавая этого.
Можно ли доверять системе распознавания лиц
Но крысиные нейроны в чашке — это завтра. Сегодня нас куда больше беспокоит доверие к системам, которые уже смотрят на нас с камер. Китай с его социальным рейтингом — самый яркий, но далеко не единственный пример. Ошибки случаются везде. Российские системы тоже путали людей. Даже 99% точности — это не 100%. А для того, кто попал в злополучный 1%, последствия могут быть катастрофичными: запрет на полёты, поезда, фактическое прикрепление к месту.
Парадокс в том, что машине мы доверяем слепо. Мы ждём от неё непогрешимости. И когда система даёт сбой, доверие рушится после трёх-четырёх громких случаев. Не кажется ли вам, что мы делегируем слишком много, не требуя взамен достаточной ответственности?

Авангард сегодняшнего дня: успешные сферы применения компьютерного зрения
И всё же, несмотря на риски, компьютерное зрение — одна из самых успешных областей ИИ. Если отбросить мрачные сценарии слежки, потенциал огромен. Камеры следят за безопасностью на опасных производствах, фиксируют, пристёгнут ли водитель ремень, находят оставленные без присмотра вещи.
Эта технология шагнула далеко за рамки «безопасного города». На Алтае с её помощью отслеживают редких снежных барсов. Нефтяные компании запускают дронов для инспекции трубопроводов. В Великобритании камеры автоматически штрафуют тех, кто выбросил мусор из окна машины. Задачи, на которые человек потратил бы часы, алгоритм решает в реальном времени.
Не отстаёт и работа с языком. Голосовые помощники, мгновенный перевод и озвучка текстов, конвертация речи в текст — всё это перестало быть фантастикой. Беспилотные автомобили и роботы-курьеры постепенно входят в норму, как и умные комбайны в полях, которые ведут борозду точнее любого тракториста.

На грани разумного: куда движется развитие нейронных сетей
А что дальше? Разработчики заглядывают ещё глубже. Первое направление — семантические сети. В отличие от нейронных, которые просто перетасовывают данные, их можно научить выстраивать абстрактные связи, почти «мыслить». Это на шаг ближе к принципам работы нашего мозга, но и требует колоссальных ресурсов. Ходят слухи, что именно над подобными проектами мог работать Сэм Альтман перед своим громким увольнением. Именно такие сети пугают больше всего — они слишком похожи на нас.
Второе направление — эмоциональный ИИ. Машину учат распознавать и, возможно, имитировать эмоции. Главное отличие человека от алгоритма — влияние чувств на решения. Безэмоциональный бот в кол-центре раздражает. А вот «эмпатичный» ассистент в службе психологической поддержки мог бы расположить к себе. Но здесь же таится и огромная опасность: представьте звонок от «взволнованной мамы», голос которой скопирован ИИ с короткой записи. Мошенники уже потирают руки.

А вот паниковать из-за генеративного ИИ вроде ChatGPT пока рано. Он не оправдывает хайп сходу: запросите у него статью или картинку без точных инструкций — и получите посредственный результат. Нужен особый навык формулировок. Да и общество пока скептически относится к «творчеству» нейросетей, считая это профанацией. Но в умелых руках — это мощный инструмент, а не замена человеку.

Как регулировать ИИ: поможет социальная ответственность
Очевидно, что пора что-то регулировать. Но как? Запреты работают только для законопослушных. Мошенники найдут обходной путь. Законотворчество всегда отстаёт: пока документ принимают, технологии успевают шагнуть вперёд. Запретили ChatGPT в некоторых странах? Люди всё равно им пользуются.
Наиболее разумный путь видится в формировании культуры осознанного использования. Нужно не бояться ИИ, а учиться с ним взаимодействовать, понимать его ограничения и риски. Звучит утопично? Возможно. Но другого выхода у нас, кажется, просто нет. В конце концов, будущее создаём мы сами — своими вопросами, решениями и той мерой ответственности, которую готовы на себя взять.










